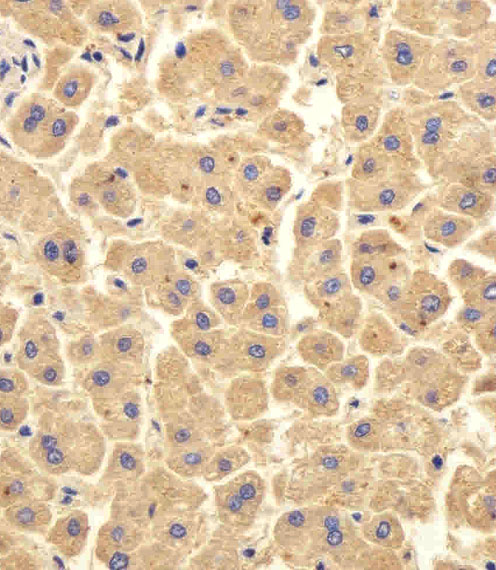

> Antigen, Antibodies, ELISA, Western Blot > Primary Antibody > Polyclonal Antibodies > UBE2D1 Antibody (C-term)Brand |
Leading Biology | Catalog Number |
APR04786G |
Product Type |
Polyclonal Antibodies | Field of Research |
|
Product Overview |
We constantly strive to ensure we provide our customers with the best antibodies. As a result of this work we offer this antibody in purified format.
We are in the process of updating our datasheets. If you have any questions regarding this update, please feel free to contact our technical support team.
This product is a high quality UBE2D1 Antibody (C-term).
|
||
Molecular Weight |
16602 Da
|
||
Cellular Localization |
Antigen Cellular Localization:
Cytoplasm.
|
||
Host |
Rabbit
|
||
Species Reactivity |
Human
|
||
Immunogen |
111-140 aa
|
||
Target |
This UBE2D1 antibody is generated from rabbits immunized with a KLH conjugated synthetic peptide between 111-140 amino acids from the C-terminal region of human UBE2D1.
|
||
Isotype |
Rabbit Ig
|
||
Symbol |
SFT, UBC5A, UBCH5, UBCH5A
|
||
GeneID |
|||
UniProt ID |
|||
Function |
Accepts ubiquitin from the E1 complex and catalyzes its covalent attachment to other proteins. In vitro catalyzes 'Lys- 48'-linked polyubiquitination. Mediates the selective degradation of short-lived and abnormal proteins. Functions in the E6/E6-AP- induced ubiquitination of p53/TP53. Mediates ubiquitination of PEX5 and auto-ubiquitination of STUB1, TRAF6 and TRIM63/MURF1. Ubiquitinates STUB1-associated HSP90AB1 in vitro. Lacks inherent specificity for any particular lysine residue of ubiquitin. Essential for viral activation of IRF3. Mediates polyubiquitination of CYP3A4.
|
||
Summary |
The modification of proteins with ubiquitin is an important cellular mechanism for targeting abnormal or short-lived proteins for degradation. Ubiquitination involves at least three classes of enzymes: ubiquitin-activating enzymes, or E1s, ubiquitin-conjugating enzymes, or E2s, and ubiquitin-protein ligases, or E3s. UBE2D1 is a member of the E2 ubiquitin-conjugating enzyme family. This enzyme is closely related to a stimulator of iron transport (SFT), and is up-regulated in hereditary hemochromatosis. It also functions in the ubiquitination of the tumor-suppressor protein p53 and the hypoxia-inducible transcription factor HIF1alpha by interacting with the E1 ubiquitin-activating enzyme and the E3 ubiquitin-protein ligases.
|
||
Storage & Stability |
Store at +4°C short term. For long-term storage, aliquot and store at -20°C or below. Stable for 12 months at -20°C. Avoid repeated freeze-thaw cycles.
|
||
Applications |
WB, IHC-P, E
|
||
Dilution |
IHC-P~~1:50~100
WB~~1:1000
|
||
Images |
Immunohistochemical analysis of paraffin-embedded H. liver section using UBE2D1 Antibody (C-term)( APR04786G). APR04786G was diluted at 1:100 dilution. A peroxidase-conjugated goat anti-rabbit IgG at 1:400 dilution was used as the secondary antibody, followed by DAB staining. 
Western blot analysis of lysates from A431, HepG2 cell line, human skeletal muscle and mouse thymus tissue lysate(from left to right), using hUBE2D1-I126(AP2112B). AP2112B was diluted at 1:1000 at each lane. A goat anti-rabbit IgG H&L(HRP) at 1:10000 dilution was used as the secondary antibody. Lysates at 35ug per lane. 
Formalin-fixed and paraffin-embedded human cancer tissue reacted with the primary antibody, which was peroxidase-conjugated to the secondary antibody, followed by DAB staining. This data demonstrates the use of this antibody for immunohistochemistry; clinical relevance has not been evaluated. BC = breast carcinoma; HC = hepatocarcinoma. |
||
Specification |
|||
Quantity |
|
||
| Select | Brand | Catalog No. | Product Name | Pack Size | Type | Field of Research | Specification | Quantity | Price(USD) | |
| 1 | Leading Biology | APR03440G | ITGA11 Antibody (N-term) | 100 μl | Polyclonal Antibodies |
|
$495.00 | Add Ask | ||
| 2 | Leading Biology | APR04537G | CMIP Antibody (C-term) | 100 μl | Polyclonal Antibodies |
|
$495.00 | Add Ask | ||
| 3 | Leading Biology | APR12422G | Human H4 Histamine Receptor (extracellular) Antibody | 50 μl | Polyclonal Antibodies |
|
$695.00 | Add Ask | ||
| 4 | Leading Biology | APR03844G | UBE2W Antibody (C-term) | 100 μl | Polyclonal Antibodies |
|
$495.00 | Add Ask | ||
| 5 | Leading Biology | APR04349G | HECTD2 Antibody (N-term) | 100 μl | Polyclonal Antibodies |
|
$495.00 | Add Ask | ||
| 6 | Leading Biology | APR03502G | IGHG1 Antibody (Center) | 100 μl | Polyclonal Antibodies |
|
$495.00 | Add Ask |
 Leading Biology Inc.
2600 Hilltop DR, Building G, B Suite C138
Richmond, CA, 94806
Tel: 1-661-524(LBI)-0262
Email: info@leadingbiology.com
Leading Biology Inc.
2600 Hilltop DR, Building G, B Suite C138
Richmond, CA, 94806
Tel: 1-661-524(LBI)-0262
Email: info@leadingbiology.com
Complete this form and click send to ask us a question, request a quote or simply say hello.

You have 0 item in your cart

You have 0 item in your inquiry list
